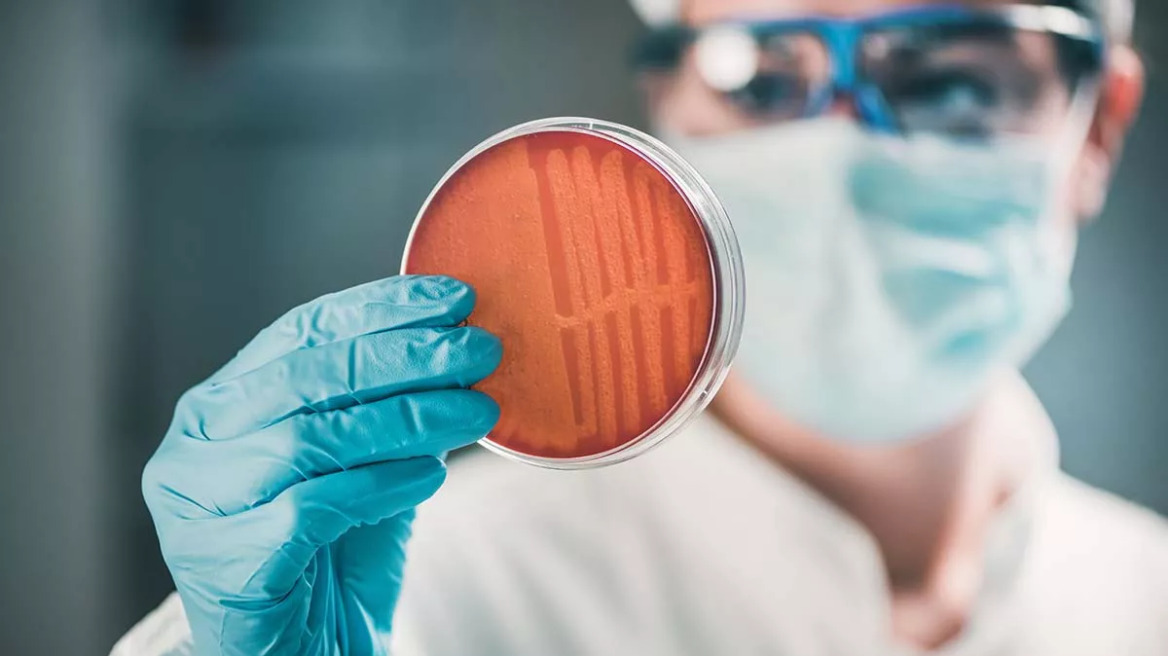
Αντιβιοτικά: Η ουσία που «αποδυναμώνει» τα ανθεκτικά μικρόβια και δίνει λύση στη μικροβιακή αντοχή

Αντιβιοτικά: Η ουσία που «αποδυναμώνει» τα ανθεκτικά μικρόβια και δίνει λύση στη μικροβιακή αντοχή
Αντιβιοτικά: Η ουσία που «αποδυναμώνει» τα ανθεκτικά μικρόβια και δίνει λύση στη μικροβιακή αντοχή
Τη λύση στο παγκόσμιο ζήτημα της αντίστασης στα αντιβιοτικά θα μπορούσε να δώσει ένας πολλά υποσχόμενος φαρμακευτικός συνδυασμός, που μειώνει σημαντικά την ικανότητα των βακτηρίων να γίνονται ανθεκτικά στα συγκεκριμένα σκευάσματα
Από την αναποτελεσματικότητα των αντιβιοτικών, λόγω της αντίστασης στα αντιβιοτικά, χάνουν κάθε χρόνο τη ζωή τους εκατομμύρια άνθρωποι, με συνολικά 1,3 εκατομμύρια θανάτους μόνο το 2019. Αυτό το αρνητικό «ρεκόρ» υπόσχεται να ελαττώσει ένα σκεύασμα, βάζοντας «φρένο» στο παγκόσμιο πρόβλημα της βακτηριακής αντοχής στα αντιβιοτικά.
Σύμφωνα με τη μελέτη, που δημοσιεύτηκε στο Science Advances, και τα πειράματα που διενέργησε η ερευνητική ομάδα από το Baylor College of Medicine σε ζωικά μοντέλα, το φάρμακο, με την ονομασία χλωριούχο δεκαλίνιο (DEQ), μειώνει σημαντικά την ικανότητα των βακτηρίων να αναπτύξουν αντίσταση στα αντιβιοτικά, γεγονός που θα μπορούσε να παρατείνει την αποτελεσματικότητα των αντιβιοτικών.
Διαβάστε περισσότερα στο ygeiamou.gr
Σύμφωνα με τη μελέτη, που δημοσιεύτηκε στο Science Advances, και τα πειράματα που διενέργησε η ερευνητική ομάδα από το Baylor College of Medicine σε ζωικά μοντέλα, το φάρμακο, με την ονομασία χλωριούχο δεκαλίνιο (DEQ), μειώνει σημαντικά την ικανότητα των βακτηρίων να αναπτύξουν αντίσταση στα αντιβιοτικά, γεγονός που θα μπορούσε να παρατείνει την αποτελεσματικότητα των αντιβιοτικών.
Διαβάστε περισσότερα στο ygeiamou.gr
Ακολουθήστε το protothema.gr στο Google News και μάθετε πρώτοι όλες τις ειδήσεις
Δείτε όλες τις τελευταίες Ειδήσεις από την Ελλάδα και τον Κόσμο, τη στιγμή που συμβαίνουν, στο Protothema.gr
Δείτε όλες τις τελευταίες Ειδήσεις από την Ελλάδα και τον Κόσμο, τη στιγμή που συμβαίνουν, στο Protothema.gr
ΡΟΗ ΕΙΔΗΣΕΩΝ
Ειδήσεις
Δημοφιλή
Σχολιασμένα















































